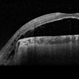

-
 By Akansha Sharma
By Akansha Sharma
Co-author(s): Dr. Urmil Shah, Bharati Eye Hospital - Uploaded on Feb 7, 2024.
- Last modified by Joshua Friedman on Feb 7, 2024.
- Rating
- Appears in
- Miscellaneous
- Condition/keywords
- RD, chorioretinal coloboma
- Photographer
- Dr. Akansha Sharma, Bharati Eye Hospital
- Imaging device
- Scanning laser ophthalmoscope
- Description
- Color fundus photograph of a 43 year old male post retinal detachment surgery in a case of iridofundal coloboma.


 Initializing download.
Initializing download.